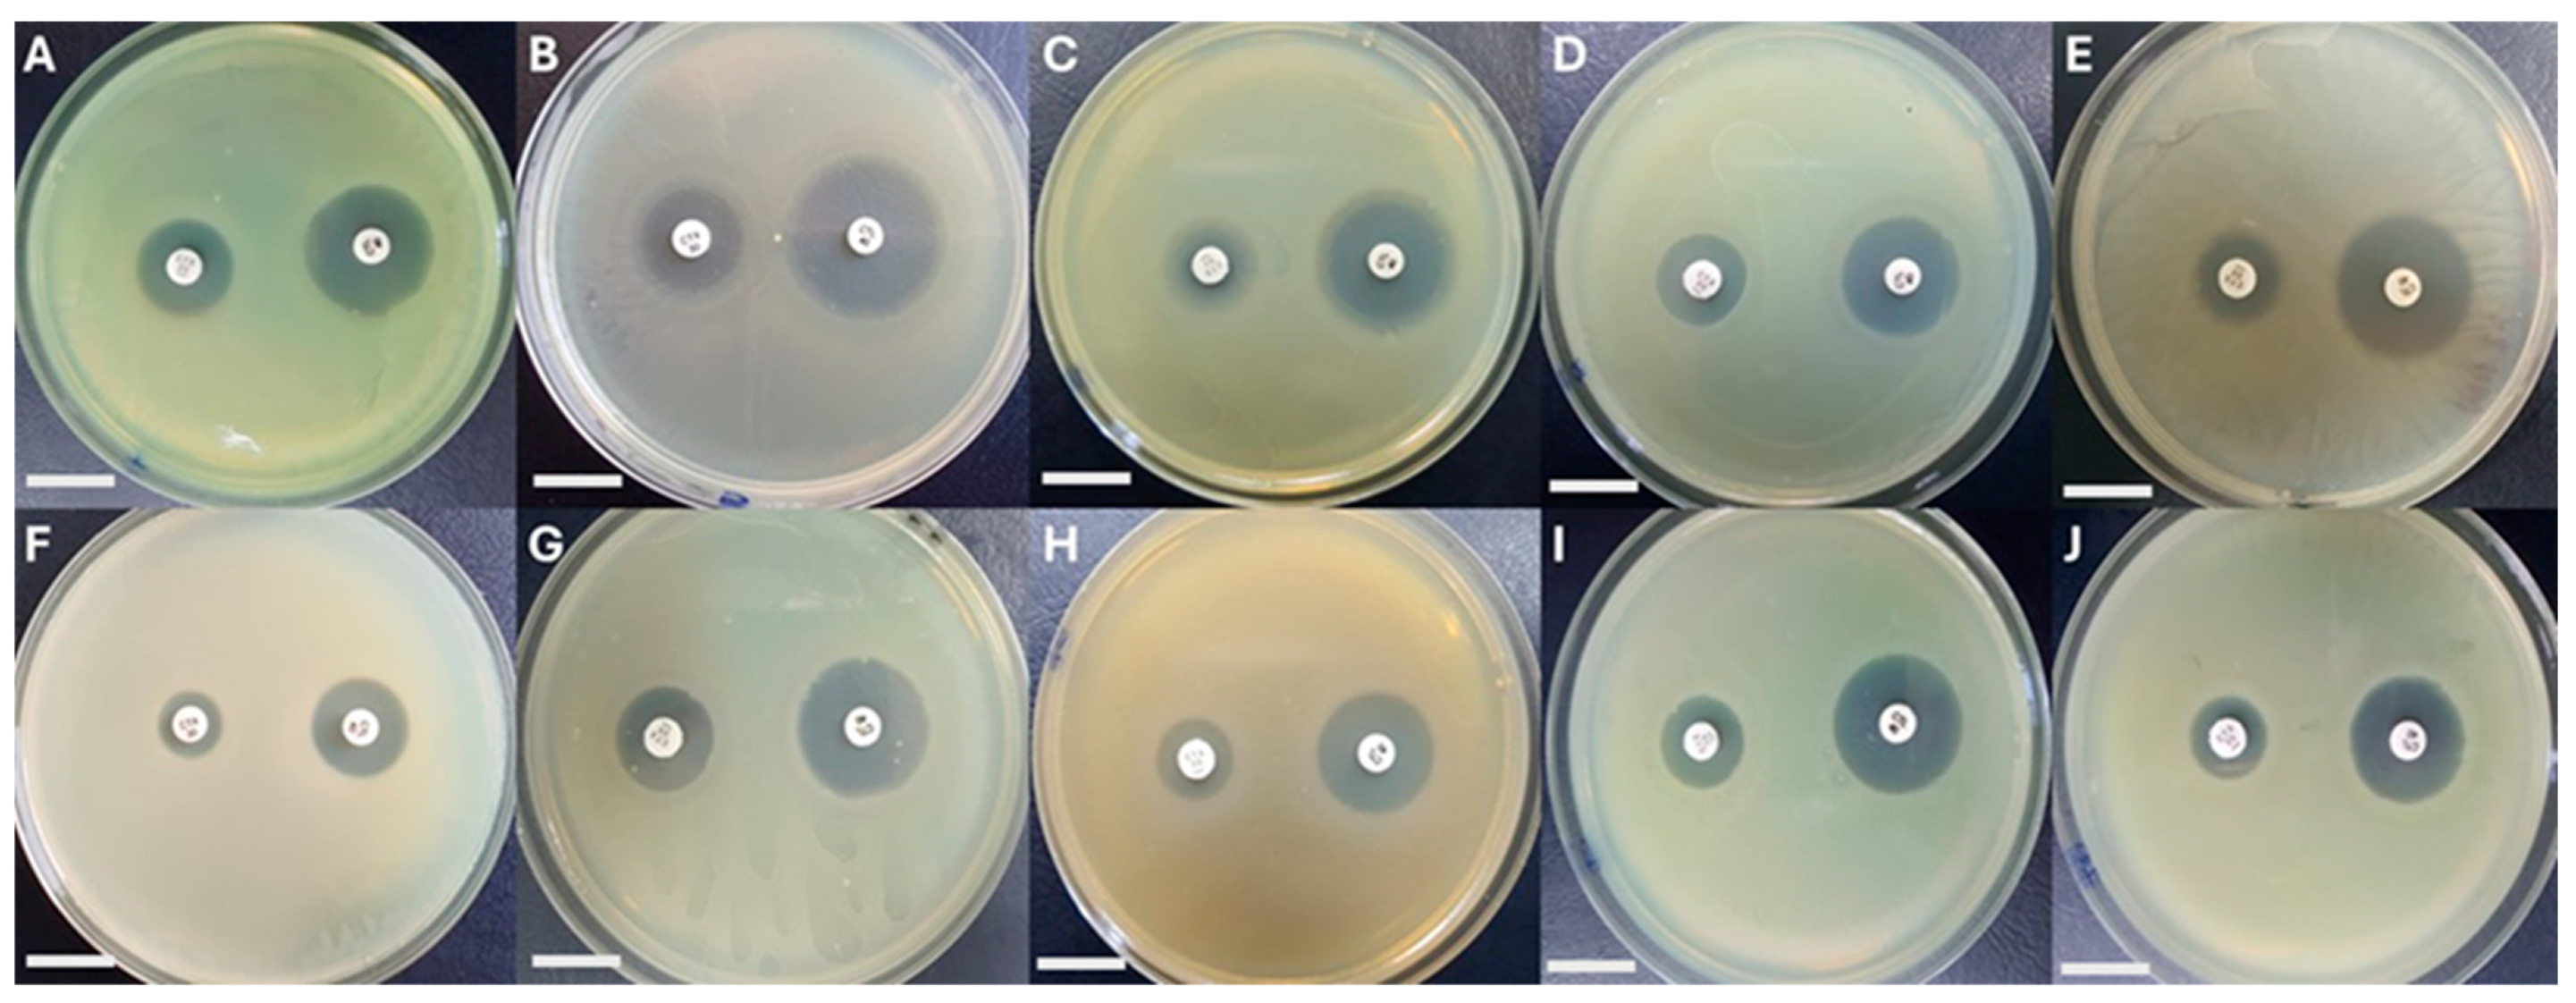
Fishes 09 00432 g003 Fishes 09 00432 g003

Occurrence of Multi-Drug-Resistant Bacteria in Rainbow Trout–Lettuce Bio-Integrated Culture Systems in Chile
Abstract
1. Introduction
2. Materials and Methods
2.1. Sampling
2.2. Bacterial Cultivable Counts
2.3. Bacterial Isolates
2.4. Bacterial Identification
2.5. Antimicrobial Susceptibility Patterns
2.6. Minimum Inhibitory Concentration (MIC) Values
2.7. Genes Encoding for Amphenicol Resistance
2.8. Genes Encoding for Sulfonamide Resistance
2.9. Phenotypic Detection of Extended-Spectrum-β-Lactamase (ESBL) Production
2.10. Class 1 Integron
2.11. Plasmid Content
2.12. Plasmid Transfer
3. Results and Discussion
4. Conclusions
Author Contributions
Funding
Institutional Review Board Statement
Data Availability Statement
Conflicts of Interest
Correction Statement
References
- Ibrahim, L.A.; Shaghaleh, H.; El-Kassar, G.M.; Abu-Hashim, M.; Elsadek, E.A.; Alhaj Hamoud, Y. Aquaponics: A Sustainable Path to Food Sovereignty and Enhanced Water Use Efficiency. Water 2023, 15, 4310. [Google Scholar] [CrossRef]
- Tyson, R.V.; Danyluk, M.D.; Simonne, E.H.; Treadwell, D.D. Sustainable aquaponic vegetable and fish co-production. Proc. Fla. State Hortic. Soc. 2012, 125, 381–385. [Google Scholar]
- Maucieri, C.; Nicoletto, C.; Junge, R.; Schmautz, Z.; Sambo, P.; Borin, M. Hydroponic Systems and Water Management in Aquaponics: A Review. Ital. J. Agron. 2017, 11, 1–11. [Google Scholar] [CrossRef]
- Schmautz, Z.; Graber, A.; Jaenicke, S.; Goesmann, A.; Junge, R.; Smits, T.H.M. Microbial Diversity in Different Compartments of an Aquaponics System. Arch. Microbiol. 2017, 199, 613–620. [Google Scholar] [CrossRef] [PubMed]
- Eck, M.; Sare, A.R.; Massart, S.; Schmautz, Z.; Junge, R.; Smits, T.H.M.; Jijakli, M.H. Exploring Bacterial Communities in Aquaponic Systems. Water 2019, 11, 260. [Google Scholar] [CrossRef]
- Kasozi, N.; Abraham, B.; Kaiser, H.; Wilhelmi, B. The complex microbiome in aquaponics: Significance of the bacterial Ecosystem. Ann. Microbiol. 2021, 71, 1. [Google Scholar] [CrossRef]
- Wongkiew, S.; Hu, Z.; Chandran, K.; Lee, J.W.; Khanal, S.K. Nitrogen transformations in aquaponic systems: A review. Aquac. Eng. 2017, 76, 9–19. [Google Scholar] [CrossRef]
- Dong, Z.; Sha, S.; Li, C.; Hashim, H.; Gao, Y.; Ong, P.; Lee, C.T.; Zhang, Z.; Wu, W.-M. Potential Risk of Antibiotics Pollution in Aquaponic System and Control Approaches. Chem. Eng. Trans. 2020, 78, 265–270. [Google Scholar] [CrossRef]
- Avendaño-Herrera, R.; Mancilla, M.; Miranda, C.D. Use of antimicrobials in Chilean Salmon farming: Facts, myths and perspectives. Rev. Aquac. 2022, 15, 89–111. [Google Scholar] [CrossRef]
- Wu, C.; Zhang, X.; Liang, J.; Li, Q.; Lin, H.; Lin, C.; Liu, H.; Zhou, D.; Lu, W.; Sun, Z.; et al. Characterization of florfenicol resistance genes in the coagulase-negative Staphylococcus (CoNS) isolates and genomic features of a multidrug-resistant Staphylococcus lentus strain H29. Antimicrob. Resist. Infect. Control 2021, 10, 9. [Google Scholar] [CrossRef]
- Guo, X.; Chen, H.; Tong, Y.; Wu, X.; Tang, C.; Qin, X.; Guo, J.; Li, P.; Wang, Z.; Liu, W.; et al. A review on the antibiotic florfenicol: Occurrence, environmental fate, effects, and health risks. Environ. Res. 2024, 244, 117934. [Google Scholar] [CrossRef] [PubMed]
- Schwarz, S.; Kehrenberg, C.; Doublet, B.; Cloeckaert, A. Molecular basis of bacterial resistance to chloramphenicol and florfenicol. FEMS Microbiol. Rev. 2004, 28, 519–542. [Google Scholar] [CrossRef] [PubMed]
- Shen, J.; Wang, Y.; Schwarz, S. Presence and dissemination of the multiresistance gene cfr in Gram-positive and Gram-negative bacteria. J. Antimicrob. Chemother. 2013, 68, 1697–1706. [Google Scholar] [CrossRef] [PubMed]
- Zhao, Q.; Wang, Y.; Wang, S.; Wang, Z.; Du, X.D.; Jiang, H.; Xia, X.; Shen, Z.; Ding, S.; Wu, C.; et al. Prevalence and abundance of florfenicol and linezolid resistance genes in soils adjacent to swine feedlots. Sci. Rep. 2016, 6, 32192. [Google Scholar] [CrossRef]
- Ceccarelli, D.; Colombo, M.M. Role, circulation and molecular characterization of integrons and ICEs in clinical and environmental Vibrio. In Communicating Current Research and Educational Topics and Trends in Applied Microbiology; A. Méndez Vilas, FORMATEX: Norristown, PA, USA, 2007; pp. 220–229. [Google Scholar]
- Le Roux, F.; Blokesch, M. Eco-evolutionary dynamics linked to horizontal gene transfer in Vibrios. Annu. Rev. Microbiol. 2018, 72, 89–110. [Google Scholar] [CrossRef]
- Brenciani, A.; Morroni, G.; Schwarz, S.; Giovanetti, E. Oxazolidinones: Mechanisms of resistance and mobile genetic elements involved. J. Antimicrob. Chemother. 2022, 77, 2596–2621. [Google Scholar] [CrossRef]
- San Millan, A. Evolution of Plasmid-Mediated Antibiotic Resistance in the Clinical Context. Trends Microbiol. 2018, 26, 978–985. [Google Scholar] [CrossRef]
- Loftie-Eaton, W.; Yano, H.; Burleigh, S.; Simmons, R.S.; Hughes, J.M.; Rogers, L.M.; Hunter, S.S.; Settles, M.L.; Forney, L.J.; Ponciano, J.M.; et al. Evolutionary paths that expand plasmid host-range: Implications for spread of antibiotic resistance. Mol. Biol. Evol. 2016, 33, 885–897. [Google Scholar] [CrossRef]
- Fluit, A.C.; Schmitz, F.J. Resistance integrons and super-integrons. Clin. Microbiol. Infect. 2004, 10, 272–288. [Google Scholar] [CrossRef]
- Gillings, M.R.; Gaze, W.H.; Pruden, A.; Smalla, K.; Tiedje, J.M.; Zhu, Y.G. Using the class 1 integron-integrase gene as a proxy for anthropogenic pollution. ISME J. 2015, 9, 1269–1279. [Google Scholar] [CrossRef]
- Miranda, C.D. Antimicrobial Resistance in Salmonid Farming. In Antimicrobial Resistance in the Environment; Monforts, M., Keen, P., Eds.; Wiley: Hoboken, NJ, USA, 2012; Chapter 22; pp. 423–451. [Google Scholar]
- Miranda, C.D.; Rojas, R. Occurrence of florfenicol resistance in bacteria associated with two Chilean salmon farms with different history of antibacterial usage. Aquaculture 2007, 266, 39–46. [Google Scholar] [CrossRef]
- Huijbers, P.M.; Blaak, H.; de Jong, M.C.; Graat, E.A.; Vandenbroucke-Grauls, C.M.; de Roda Husman, A.M. Role of the Environment in the Transmission of Antimicrobial Resistance to Humans: A Review. Environ. Sci. Technol. 2015, 49, 11993–12004. [Google Scholar] [CrossRef] [PubMed]
- APHA. Microbiological examination. In Standard Methods for the Examination of Water and Wastewater, 18th ed.; Greenberg, A.E., Clesceri, L.S., Eaton, A.D., Eds.; American Public Health Association: Washington, DC, USA, 1992; pp. 9.1–9.147. [Google Scholar]
- Opazo, R.; Ortúzar, F.; Navarrete, P.; Espejo, R.; Romero, J. Reduction of soybean meal non-starch polysaccharides and α-Galactosides by solid-state fermentation using cellulolytic bacteria obtained from different environments. PLoS ONE 2012, 7, e44783. [Google Scholar] [CrossRef] [PubMed]
- Ribosomal Database Project. Available online: https://sourceforge.net/projects/rdp-classifier/ (accessed on 22 April 2024).
- CLSI. Performance Standards for Antimicrobial Disk Susceptibility Test, 12th ed.; Approved Standard, M02-A12; Clinical and Laboratory Standards Institute: Wayne, NJ, USA, 2015. [Google Scholar]
- CLSI. Performance Standards for Antimicrobial Susceptibility Testing, 30th ed.; CLSI Document M100-S27; Clinical and Laboratory Standards Institute: Wayne, PA, USA, 2020. [Google Scholar]
- CLSI. Methods for Dilution Antimicrobial Susceptibility Tests for Bacteria that Grow Aerobically, 10th ed.; Approved Standard M07-A10; Clinical and Laboratory Standards Institute: Wayne, NJ, USA, 2015. [Google Scholar]
- Hurtado, L.; Miranda, C.D.; Rojas, R.; Godoy, F.A.; Añazco, M.A.; Romero, J. Live Feeds Used in the Larval Culture of Red Cusk Eel, Genypterus chilensis, Carry High Levels of Antimicrobial-Resistant Bacteria and Antibiotic-Resistance Genes (ARGs). Animals 2020, 10, 505. [Google Scholar] [CrossRef]
- Domínguez, M.; Miranda, C.D.; Fuentes, O.; de la Fuente, M.; Godoy, F.A.; Bello-Toledo, H.; González-Rocha, G. Occurrence of Transferable Integrons and sul and dfr Genes Among Sulfonamide-and/or Trimethoprim-Resistant Bacteria Isolated From Chilean Salmonid Farms. Front. Microbiol. 2019, 10, 748. [Google Scholar] [CrossRef]
- Singer, R.S.; Patterson, S.K.; Meier, A.E.; Gibson, J.K.; Lee, H.L.; Maddox, C.W. Relationship between phenotypic and genotypic florfenicol resistance in Escherichia coli. Antimicrob. Agents. Chemother. 2004, 48, 4047–4049. [Google Scholar] [CrossRef]
- Higuera-Llantén, S.; Vásquez-Ponce, F.; Barrientos-Espinoza, B.; Mardones, F.O.; Marshall, S.H.; Olivares-Pacheco, J. Extended antibiotic treatment in salmon farms select multiresistant gut bacteria with a high prevalence of antibiotic resistance genes. PLoS ONE 2018, 13, e0203641. [Google Scholar] [CrossRef]
- Qiu, J.; Jiang, Z.; Ju, Z.; Zhao, X.; Yang, J.; Guo, H.; Sun, S. Molecular and Phenotypic Characteristics of Escherichia coli Isolates from Farmed Minks in Zhucheng, China. BioMed Res. Int. 2019, 2019, 3917841. [Google Scholar] [CrossRef]
- Lang, K.S.; Anderson, J.M.; Schwarz, S.; Williamson, L.; Handelsman, J.; Singer, R.S. Novel florfenicol and chloramphenicol resistance gene discovered in alaskan soil by using functional metagenomics. Appl. Environ. Microbiol. 2010, 76, 5321–5326. [Google Scholar] [CrossRef]
- Li, P.; Zhu, T.; Zhou, D.; Lu, W.; Liu, H.; Sun, Z.; Ying, J.; Lu, J.; Lin, X.; Li, K.; et al. Analysis of Resistance to Florfenicol and the Related Mechanism of Dissemination in Different Animal-Derived Bacteria. Front. Cell. Infect. Microbiol. 2020, 10, 369. [Google Scholar] [CrossRef]
- Shore, A.C.; Brennan, O.M.; Ehricht, R.; Monecke, S.; Schwarz, S.; Slickers, P.; Coleman, D.C. Identification and characterization of the multidrug resistance gene cfr in a Panton-Valentine leukocidin-positive sequence type 8 methicillin-resistant Staphylococcus aureus IVa (USA300) isolate. Antimicrob. Agents Chemother. 2010, 54, 4978–4984. [Google Scholar] [CrossRef] [PubMed]
- De Gheldre, Y.; Avesani, V.; Berhin, C.; Delmée, M.; Glupczynski, Y. Evaluation of Oxoid combination discs for detection of extended-spectrum β-lactamases. J. Antimicrob. Chemother. 2003, 52, 591–597. [Google Scholar] [CrossRef] [PubMed]
- Dey, T.K.; Lindahl, J.F.; Lundkvist, A.; Grace, D.; Deka, R.P.; Shome, R.; Bandyopadhyay, S.; Goyal, N.K.; Sharma, G.; Shome, B.R. Analyses of Extended-Spectrum-β-Lactamase, Metallo-β-Lactamase, and AmpC-β-Lactamase Producing Enterobacteriaceae from the Dairy Value Chain in India. Antibiotics 2023, 12, 1449. [Google Scholar] [CrossRef] [PubMed]
- Miranda, C.D.; Concha, C.; Hurtado, L.; Urtubia, R.; Rojas, R.; Romero, J. Occurrence of Antimicrobial-Resistant Bacteria in Intestinal Contents of Wild Marine Fish in Chile. Antibiotics 2024, 13, 332. [Google Scholar] [CrossRef] [PubMed]
- Iqbal, R.; Ikram, N.; Shoaib, M.; Asad, M.J.; Mehmood, R.T.; Niazi, A.; Asghar, A.; Ishfaq, B.; Naseer, F. Phenotypic confirmatory disc diffusion test (PCDDT), double disc synergy test (DDST), E-test OS diagnostic tool for detection of extended spectrum beta lactamase (ESBL) producing Uropathogens. J. Appl. Biotechnol. Bioeng. 2017, 3, 344–349. [Google Scholar] [CrossRef][Green Version]
- Rasheed, J.K.; Anderson, G.J.; Yigit, H.; Queenan, A.M.; Doménech-Sánchez, A.; Swenson, J.M.; Biddle, J.W.; Ferraro, M.J.; Jacoby, G.A.; Tenover, F.C. Characterization of the extended-spectrum β-lactamase reference strain, Klebsiella pneumoniae K6 (ATCC 700603), which produces the novel enzyme SHV-18. Antimicrob. Agents Chemother. 2000, 44, 2382–2388. [Google Scholar] [CrossRef]
- Malwade, A.; Nguyen, A.; Sadat-Mousavi, P.; Ingalls, B.P. Predictive Modeling of a Batch Filter Mating Process. Front. Microbiol. 2017, 8, 461. [Google Scholar] [CrossRef]
- Gomila, M.; Peña, A.; Mulet, M.; Lalucat, J.; García-Valdés, E. Phylogenomics and systematics in Pseudomonas. Front. Microbiol. 2015, 6, 214. [Google Scholar] [CrossRef]
- Girard, L.; Lood, C.; Höfte, M.; Vandamme, P.; Rokni-Zadeh, H.; van Noort, V.; Lavigne, R.; De Mot, R. The Ever-Expanding Pseudomonas Genus: Description of 43 New Species and Partition of the Pseudomonas putida Group. Microorganisms 2021, 9, 1766. [Google Scholar] [CrossRef]
- Schmautz, Z.; Walser, J.-C.; Espinal, C.A.; Gartmann, F.; Scott, B.; Pothier, J.F.; Frossard, E.; Junge, R.; Smits, T.H.M. Microbial diversity across compartments in an aquaponic system and its connection to the nitrogen cycle. Sci. Total Environ. 2022, 852, 158426. [Google Scholar] [CrossRef]
- Ruiz, A.; Scicchitano, D.; Palladino, G.; Nanetti, E.; Candela, M.; Furones, D.; Sanahuja, I.; Carbó, R.; Gisbert, E.; Andree, K.B. Microbiome study of a coupled aquaponic system: Unveiling the independency of bacterial communities and their beneficial influences among different compartments. Sci. Rep. 2023, 13, 19704. [Google Scholar] [CrossRef] [PubMed]
- Miranda, C.D.; Zemelman, R. Antimicrobial multiresistance in bacteria isolated from freshwater Chilean salmon farms. Sci. Total Environ. 2002, 293, 207–218. [Google Scholar] [CrossRef] [PubMed]
- Navarro, A.; Sanseverino, I.; Cappelli, F.; Lahm, A.; Niegowska, M.; Fabbri, M.; Paracchini, V.; Petrillo, M.; Skejo, H.; Valsecchi, S.; et al. Study of antibiotic resistance in freshwater ecosystems with low anthropogenic impact. Sci. Total Environ. 2023, 857, 159378. [Google Scholar] [CrossRef] [PubMed]
- Fernández-Alarcón, C.; Miranda, C.D.; Singer, R.S.; López, Y.; Rojas, R.; Bello, H.; Domínguez, M.; González-Rocha, G. Detection of the floR gene in a diversity of florfenicol resistant Gram-negative bacilli from freshwater salmon farms in Chile. Zoonoses Public Health 2010, 57, 181–188. [Google Scholar] [CrossRef]
- Goldberg, J.; Hancock, R.E.W.; Parales, R.E.; Loper, J.; Cornelis, P. Pseudomonas 2007. J. Bacteriol. 2007, 190, 2649–2662. [Google Scholar] [CrossRef]
- WHO. Prioritization of Pathogens to Guide Discovery, Research and Development of New Antibiotics for Drug-Resistant Bacterial Infections, Including Tuberculosis. 2017. Available online: https://www.who.int/publications/i/item/WHO-EMP-IAU-2017.12 (accessed on 12 July 2024).
- Joyce, A.; Timmons, M.; Goddek, S.; Pentz, T. Bacterial Relationships in Aquaponics: New Research Directions. In Aquaponics Food Production Systems, 1st ed.; Goddek, S., Joyce, A., Kotzen, B., Burnell, G.M., Eds.; Springer: Cham, Switzerland, 2019; Chapter 6; pp. 45–161. [Google Scholar]
- Mori, J.; Smith, R. Transmission of waterborne fish and plant pathogens in aquaponics and their control with physical disinfection and filtration: A systematized review. Aquaculture 2019, 504, 380–395. [Google Scholar] [CrossRef]
- Dorick, J.; Kumar, G.D.; Macarisin, D.; Widmer, J.A.; Stivers, T.; Dunn, L.L. Longitudinal survey of Aeromonas hydrophila and foodborne pathogens in a comercial aquaponics system. J. Food Prot. 2024, 87, 100230. [Google Scholar] [CrossRef]
- Antaki, E.; Taber, S.; Jay-Russell, M. Potential Zoonotic Risks in Aquaponics. IAFP, Portland. 2015. Available online: https://iafp.confex.com/iafp/2015/webprogram/Paper8866.html (accessed on 21 October 2024).
- WHO; World Organisation for Animal Health (OIE). OIE List of Antimicrobial Agents of Veterinary Importance; OIE: Paris, France, 2015; 9p. [Google Scholar]
- WHO; Advisory Group on Integrated Surveillance of Antimicrobial Resistance (AGISAR). Critically Important Antimicrobials for Human Medicine; 5th Revision; World Health Organization: Geneva, Switzerland, 2016; 41p. [Google Scholar]
- Li, D.; Wang, Y.; Schwarz, S.; Cai, J.; Fan, R.; Li, J.; Feßler, A.T.; Zhang, R.; Wu, C.; Shen, J. Co-location of the oxazolidinone resistance genes optrA and cfr on a multi-resistance plasmid from Staphylococcus sciuri. J. Antimicrobial Chemother. 2016, 71, 1474–1478. [Google Scholar] [CrossRef]
- Arcangioli, M.A.; Leroy-Sétrin, S.; Martel, J.L.; Chaslus-Dancla, E. A new chloramphenicol and florfenicol resistance gene flanked by two integron structures in Salmonella typhimurium DT104. FEMS Microbiol. Lett. 1999, 174, 327–332. [Google Scholar] [CrossRef]
- Bischoff, K.M.; White, D.G.; Hume, M.E.; Poole, T.L.; Nisbet, D.J. The chloramphenicol Resistance gene cmlA is disseminated on transferable plasmids that confer multiple-drug resistance in swine Escherichia coli. FEMS Microbiol. Lett. 2005, 243, 285–291. [Google Scholar] [CrossRef]
- Adesoji, A.T.; Call, D.R. Molecular analysis of florfenicol-resistant bacteria isolated from drinking water distribution systems in Southwestern Nigeria. J. Glob. Antimicrob. Resist. 2020, 23, 340–344. [Google Scholar] [CrossRef] [PubMed]
- Zhang, T.; Ding, Y.; Peng, J.; Dai, Y.; Luo, S.; Liu, W.; Ma, Y. Effects of Broad-Spectrum Antibiotic (Florfenicol) on Resistance Genes and Bacterial Community Structure of Water and Sediments in an Aquatic Microcosm Model. Antibiotics 2022, 11, 1299. [Google Scholar] [CrossRef] [PubMed]
- Kehrenberg, C.; Schwarz, S. fexA, a novel Staphylococcus lentus gene encoding resistance to florfenicol and chloramphenicol. Antimicrob. Agents Chemother. 2004, 48, 615–618. [Google Scholar] [CrossRef]
- Liu, H.; Wang, Y.; Wu, C.; Schwarz, S.; Shen, Z.; Jeon, B.; Ding, S.; Zhang, Q.; Shen, J. A novel phenicol exporter gene, fexB, found in enterococci of animal origin. J. Antimicrob. Chemother. 2012, 67, 322–325. [Google Scholar] [CrossRef] [PubMed]
- Sharkey, L.K.R.; O’Neill, A.J. Antibiotic resistance ABC-F proteins: Bringing target protection into the limelight. ACS Infect. Dis. 2018, 4, 239–246. [Google Scholar] [CrossRef] [PubMed]
- Kehrenberg, C.; Schwarz, S.; Jacobsen, L.; Hansen, L.H.; Vester, B. A new mechanism for chloramphenicol, florfenicol and clindamycin resistance: Methylation of 23S ribosomal RNA at A2503. Mol. Microbiol. 2005, 57, 1064–1073. [Google Scholar] [CrossRef]
- Roberts, M.C.; Schwarz, S. Tetracycline and Phenicol Resistance Genes and Mechanisms: Importance for Agriculture, the Environment, and Humans. J. Environ. Qual. 2016, 45, 576–592. [Google Scholar] [CrossRef]
- Desomer, J.; Vereecke, D.; Crespi, M.; Montagu, M. The Plasmid-Encoded Chloramphenicol-Resistance Protein of Rhodococcus fascians Is Homologous to the Transmembrane Tetracycline Efflux Proteins. Mol. Microbiol. 1992, 6, 2377–2385. [Google Scholar] [CrossRef]
- Tauch, A.; Zheng, Z.; Pühler, A.; Kalinowski, J. Corynebacterium striatum Chloramphenicol Resistance Transposon Tn5564: Genetic Organization and Transposition in Corynebacterium glutamicum. Plasmid 1998, 40, 126–139. [Google Scholar] [CrossRef]
- Antonelli, A.; D’Andrea, M.M.; Brenciani, A.; Galeotti, C.L.; Morroni, G.; Pollini, S.; Varaldo, P.E.; Rossolini, G.M. Characterization of poxtA, a novel phenicol–oxazolidinone–tetracycline resistance gene from an MRSA of clinical origin. J. Antimicrob. Chemother. 2018, 73, 1763–1769. [Google Scholar] [CrossRef]
- Tao, W.; Lee, M.H.; Wu, J.; Kim, H.; Kim, J.C.; Chung, E.; Hwang, E.C.; Lee, S.W. Inactivation of chloramphenicol and florfenicol by a novel chloramphenicol hydrolase. Appl. Environ. Microbiol. 2012, 78, 6295–6301. [Google Scholar] [CrossRef] [PubMed]
- Du, D.; Wang-Kan, X.; Neuberger, A.; van Veen, H.W.; Pos, K.M.; Piddock, L.J.V.; Luisi, B.F. Multidrug efflux pumps: Structure, function and regulation. Nat. Rev. Microbiol. 2018, 16, 523–539. [Google Scholar] [CrossRef] [PubMed]
- Masuda, N.; Sakagawa, E.; Ohya, S.; Gotoh, N.; Tsujimoto, H.; Nishino, T. Substrate Specificities of MexAB–OprM, MexCD–OprJ, and MexXY–OprM Efflux Pumps in Pseudomonas aeruginosa. Antimicrob. Agents Chemother. 2000, 44, 3322–3327. [Google Scholar] [CrossRef] [PubMed]
- Blair, J.M.A.; Richmond, G.E.; Piddock, L.J.V. Multidrug efflux pumps in Gram-negative bacteria and their role in antibiotic resistance. Future Microbiol. 2014, 9, 1165–1177. [Google Scholar] [CrossRef] [PubMed]
- Jamal, Z.; Gholami, M.; Ebrahimzadeh, M.A.; Goli, H.R. The Role of MexCD-OprJ and MexEF-OprN Efflux Systems in the Multiple Antibiotic Resistance of Pseudomonas aeruginosa Isolated from Clinical Samples. Curr. Microbiol. 2023, 80, 221. [Google Scholar] [CrossRef]
- Vinué, L.; Sáenz, Y.; Rojo-Bezares, B.; Olarte, I.; Undabeitia, E.; Somalo, S.; Zarazaga, M.; Torres, C. Genetic environment of sul genes and characterisation of integrons in Escherichia coli isolates of blood origin in a Spanish hospital. Int. J. Antimicrob. Agents 2010, 35, 492–496. [Google Scholar] [CrossRef]
- Poey, M.E.; Azpiroz, M.F.; Laviña, M. On sulfonamide resistance, sul genes, class 1 integrons and their horizontal transfer in Escherichia coli. Microb. Pathog. 2019, 135, 103611. [Google Scholar] [CrossRef]
- Rosser, S.; Young, H.-K. Identification and characterization of class 1 integrons in bacteria from an aquatic environment. J. Antimicrob. Chemother. 1999, 44, 11–18. [Google Scholar] [CrossRef]
- Bush, K.; Jacoby, G.A. Updated functional classification of beta-lactamases. Antimicrob. Agents Chemother. 2010, 54, 969–976. [Google Scholar] [CrossRef]
- Evans, J.; Hanoodi, M.; Wittler, M. Amoxicillin Clavulanate. In StatPearls [Internet]; StatPearls Publishing: Treasure Island, FL, USA, 2023. Available online: https://www.ncbi.nlm.nih.gov/books/NBK538164/ (accessed on 5 July 2024).
- Aibinu, I.; Nwanneka, T.; Odugbemi, T. Occurrence of ESBL and MBL in clinical isolates of Pseudomonas aeruginosa from Lagos, Nigeria. J. Am. Sci. 2007, 3, 81–85. [Google Scholar]

| Source | Months | ||||||||
|---|---|---|---|---|---|---|---|---|---|
| October 2022 | November 2022 | December 2022 | |||||||
| TBCC ± S.D. (CFU mL−1) | FLOR ± S.D. (%) | OXYR ± S.D. (%) | TBCC ± S.D. (CFU mL−1) | FLOR ± S.D. (%) | OXYR ± S.D. (%) | TBCC ± S.D. (CFU mL−1) | FLOR ± S.D. (%) | OXYR ± S.D. (%) | |
| Site 1 | |||||||||
| Fish Tank | 9.2 × 105 ± 0.3 × 104 | 0.02 ± 0.002 | <0.001 | 7.4 × 106 ± 0.2 × 105 | 0.50 ± 0.05 | <0.001 | 5.3 × 107 ± 0.7 × 106 | 1.80 ± 0.20 | <0.001 |
| Biofilter | 6.1 × 105 ± 0.5 × 104 | 0.02 ± 0.006 | <0.001 | 9.6 × 106 ± 0.8 × 105 | 0.30 ± 0.07 | <0.001 | 7.3 × 107 ± 0.3 × 106 | 0.80 ± 0.10 | <0.001 |
| Lettuce | 5.1 × 105 ± 0.6 × 104 | 0.01 ± 0.003 | <0.001 | 5.6 × 106 ± 0.7 × 105 | 1.00 ± 0.20 | <0.001 | 3.3 × 107 ± 0.5 × 106 | 2.10 ± 0.52 | <0.001 |
| Site 2 | |||||||||
| Fish Tank | 2.1 × 105 ± 0.2 × 104 | 0.30 ± 0.010 | <0.001 | 3.5 × 106 ± 0.4 × 105 | 0.90 ± 0.03 | <0.001 | 4.4 × 107 ± 0.2 × 106 | 2.40 ± 0.40 | <0.001 |
| Biofilter | 4.1 × 105 ± 0.4 × 104 | 0.10 ± 0.060 | <0.001 | 7.6 × 106 ± 0.3 × 105 | 1.50 ± 0.20 | <0.001 | 4.3 × 107 ± 0.6 × 106 | 1.70 ± 0.21 | <0.001 |
| Letucce | 3.1 × 105 ± 0.8 × 104 | 0.04 ± 0.008 | <0.001 | 6.6 × 106 ± 0.5 × 105 | 2.80 ± 0.50 | <0.001 | 6.9 × 107 ± 0.7 × 106 | 3.10 ± 0.50 | <0.001 |
| Isolate | Source | System | Accession No. | Closest Species (% Identity) |
|---|---|---|---|---|
| BS1 | Hydroponic culture | 1 | SRX21380217 | Pseudomonas sp. (99.0) |
| BS2 | Fish tank | 1 | SRX21380218 | Pseudomonas fluorescens (99.7) |
| BS3 | Fish tank | 1 | SRX21380227 | Pseudomonas granadensis (100) |
| BS4 | Biofilter | 1 | SRX21380228 | Psudomonas atagonensis (99.8) |
| BS5 | Biofilter | 2 | SRX21380229 | Pseudomonas alcaliphila (99.1) |
| BS6 | Biofilter | 2 | SRX21380230 | Pseudomonas salomonii (98.0) |
| BS7 | Fish tank | 2 | SRX21380231 | Pseudomonas brassicacearum (99.3) |
| BS8 | Fish tank | 2 | SRX21380232 | Pseudomonas putida (99.7) |
| BS9 | Hydroponic culture | 2 | SRX21380233 | Pseudomonas sp. (100) |
| BS10 | Fish tank | 1 | SRX21380234 | Pseudomonas germanica (99.7) |
| BS11 | Fish tank | 1 | SRX21380219 | Pseudomonas allii (98.8) |
| BS12 | Biofilter | 1 | SRX21380220 | Pseudomonas reinekei (99.3) |
| BS13 | Hydroponic culture | 1 | SRX21380221 | Pseudomonas reinekei (99.3) |
| BS14 | Hydroponic culture | 2 | SRX21380222 | Pseudomonas protegens (99.9) |
| BS15 | Fish tank | 2 | SRX21380223 | Pseudomonas plecoglossicida (100) |
| BS16 | Biofilter | 2 | SRX21380224 | Pseudomonas protegens (100) |
| BS17 | Fish tank | 1 | SRX21380225 | Pseudomonas soyae (99.4) |
| BS18 | Fish tank | 2 | SRX21380226 | Pseudomonas juntendi (99.8) |
| Isolate | MIC * | Antimicrobial Resistance Pattern | Plasmid No (in Kb) | Class 1 Integron | Sulfonamide-Resistance Gene | Amphenicol-Resistance Gene | |||||||
|---|---|---|---|---|---|---|---|---|---|---|---|---|---|
| sul1 | sul2 | cmlA | floR | fexA | fexB | optrA | pexA | cfr | |||||
| BS1 | 128 | AMO, AMC, CTT, CTX, AZT, STR, ERY, CHL, FLO, FUR, SDX, TMP, SXT | 0 | - | - | - | - | + | - | - | - | - | - |
| BS2 | 128 | AMO, AZT, STR, KAN, CHL, FLO, FUR, SDX, TMP, SXT | 1 (50) | - | + | - | - | - | - | - | - | - | - |
| BS3 | 64 | AMO, AMC, CTT, CTX, AZT, ERY, CHL, FLO, FUR, TMP | 2 (50/100) | - | - | - | + | - | - | - | - | - | - |
| BS4 | 128 | AMO, AMC, CTT, CTX, AZT, ERY, CHL, FLO, FUR, TMP | 1 (50) | - | - | - | - | - | - | - | - | - | - |
| BS5 | 64 | AMO, AZT, STR, CHL, FLO, FUR, | 0 | - | - | - | - | - | - | - | - | - | - |
| BS6 | 256 | AMO, CTT, CTX, AZT, STR, ERY, CHL, FLO, FUR, SDX, TMP, SXT | 1 (50) | - | - | - | - | - | - | - | - | - | - |
| BS7 | 128 | AMO, CTT, CTX, AZT, STR, ERY, CHL, FLO, FUR, SDX, TMP, SXT | 1 (50) | - | - | - | - | + | - | - | - | - | - |
| BS8 | 64 | AMO, AMC, CTT, CTX, AZT, ERY, CHL, FLO, FUR, SDX, TMP, SXT | 2 (50/100) | - | - | - | - | + | - | - | - | - | - |
| BS9 | 128 | AMO, AMC, CTT, CTX, AZT, MER, STR, ERY, CHL, FLO, FUR, SDX, TMP, SXT | 0 | - | - | - | - | - | - | - | - | - | - |
| BS10 | 128 | AMO, AMC, CTT, CTX, AZT, CHL, FLO, FUR, TMP | 1 (50) | - | - | - | - | + | - | - | - | - | - |
| BS11 | 128 | AMO, AMC, ERY, CHL, FLO, FUR, TMP | 1 (50) | - | - | - | + | - | - | - | - | - | - |
| BS12 | 128 | AMO, AMC, CTT, CTX, AZT, STR, ERY, CHL, FLO, FUR, SDX, TMP, SXT | 0 | - | - | - | - | - | - | - | - | - | - |
| BS13 | 64 | AMO, AMC, STR, CTT, CTX, AZT, ERY, CHL, FLO, FUR, SDX, TMP, SXT | 0 | - | - | - | - | + | - | - | - | - | - |
| BS14 | 128 | AMO, AMC, STR, CTT, CTX, AZT, ERY, CHL, FLO, FUR, SDX, TMP, SXT | 1 (20) | - | - | - | - | - | - | - | - | - | - |
| BS15 | 64 | AMO, CTT, CTX, AZT, STR, ERY, CHL, FLO, FUR, SDX, TMP, SXT | 0 | - | - | - | - | - | - | - | - | - | - |
| BS16 | 128 | AMO, AMC, CTT, CTX, AZT, STR, ERY, CHL, FLO, FUR, TMP | 1 (20) | - | - | - | - | - | - | - | - | - | - |
| BS17 | 128 | AMO, AMC, CTT, CTX, AZT, ERY, CHL, FLO, FUR, TMP | 0 | - | - | - | - | - | - | - | - | - | - |
| BS18 | 128 | AMO, CTT, CTX, AZT, STR, ERY, CHL, FLO, FUR, SDX, TMP, SXT | 1 (50) | - | - | - | - | - | - | - | - | - | - |
Disclaimer/Publisher’s Note: The statements, opinions and data contained in all publications are solely those of the individual author(s) and contributor(s) and not of MDPI and/or the editor(s). MDPI and/or the editor(s) disclaim responsibility for any injury to people or property resulting from any ideas, methods, instructions or products referred to in the content. |
© 2024 by the authors. Licensee MDPI, Basel, Switzerland. This article is an open access article distributed under the terms and conditions of the Creative Commons Attribution (CC BY) license (https://creativecommons.org/licenses/by/4.0/).
Share and Cite
Concha, C.; Hurtado, L.; Pérez, N.; Merino, G.E.; Miranda, C.D. Occurrence of Multi-Drug-Resistant Bacteria in Rainbow Trout–Lettuce Bio-Integrated Culture Systems in Chile. Fishes 2024, 9, 432. https://doi.org/10.3390/fishes9110432
Concha C, Hurtado L, Pérez N, Merino GE, Miranda CD. Occurrence of Multi-Drug-Resistant Bacteria in Rainbow Trout–Lettuce Bio-Integrated Culture Systems in Chile. Fishes. 2024; 9(11):432. https://doi.org/10.3390/fishes9110432
Chicago/Turabian StyleConcha, Christopher, Luz Hurtado, Norma Pérez, German E. Merino, and Claudio D. Miranda. 2024. "Occurrence of Multi-Drug-Resistant Bacteria in Rainbow Trout–Lettuce Bio-Integrated Culture Systems in Chile" Fishes 9, no. 11: 432. https://doi.org/10.3390/fishes9110432
APA StyleConcha, C., Hurtado, L., Pérez, N., Merino, G. E., & Miranda, C. D. (2024). Occurrence of Multi-Drug-Resistant Bacteria in Rainbow Trout–Lettuce Bio-Integrated Culture Systems in Chile. Fishes, 9(11), 432. https://doi.org/10.3390/fishes9110432

